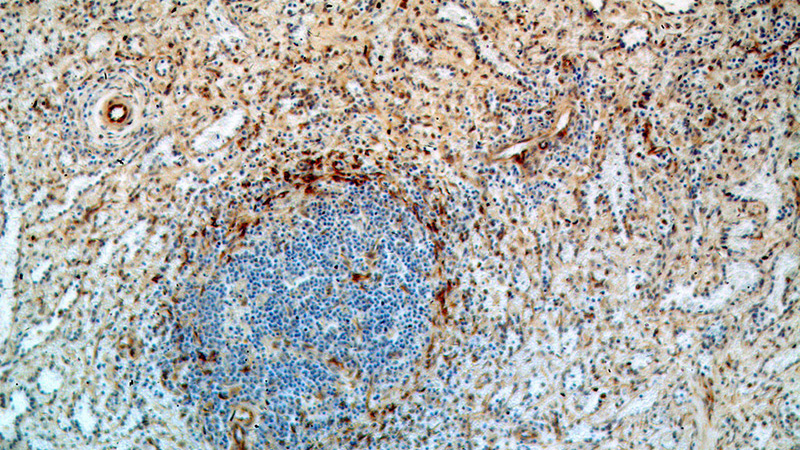
Immunohistochemical of paraffin-embedded human spleen using Catalog No:116105(TMEM173 antibody) at dilution of 1:100 (under 10x lens)

-
Product Name
TMEM173 antibody
- Documents
-
Description
TMEM173 Rabbit Polyclonal antibody. Positive IP detected in mouse spleen tissue. Positive WB detected in mouse thymus tissue, HEK-293 cells, human heart tissue, mouse spleen tissue, Raji cells, rat heart tissue. Positive IHC detected in human spleen tissue, human tonsillitis tissue. Positive IF detected in MCF-7 cells. Positive FC detected in MCF-7 cells. Observed molecular weight by Western-blot: 40kd,80kd
-
Tested applications
ELISA, WB, IHC, FC, IF, IP
-
Species reactivity
Human, Mouse, Rat; other species not tested.
-
Alternative names
FLJ38577 antibody; hMITA antibody; hSTING antibody; Mediator of IRF3 activation antibody; MITA antibody; MPYS antibody; NET23 antibody; STING antibody; TMEM173 antibody; transmembrane protein 173 antibody
-
Isotype
Rabbit IgG
-
Preparation
This antibody was obtained by immunization of TMEM173 recombinant protein (Accession Number: NM_198282). Purification method: Antigen affinity purified.
-
Clonality
Polyclonal
-
Formulation
PBS with 0.02% sodium azide and 50% glycerol pH 7.3.
-
Storage instructions
Store at -20℃. DO NOT ALIQUOT
-
Applications
Recommended Dilution:
WB: 1:500-1:5000
IP: 1:500-1:5000
IHC: 1:20-1:200
IF: 1:20-1:200
-
Validations

mouse thymus tissue were subjected to SDS PAGE followed by western blot with Catalog No:116105(TMEM173 antibody) at dilution of 1:500
Immunohistochemical of paraffin-embedded human spleen using Catalog No:116105(TMEM173 antibody) at dilution of 1:100 (under 10x lens)

Immunohistochemical of paraffin-embedded human spleen using Catalog No:116105(TMEM173 antibody) at dilution of 1:100 (under 40x lens)

IP Result of anti-TMEM173 (IP:Catalog No:116105, 4ug; Detection:Catalog No:116105 1:1000) with mouse spleen tissue lysate 4000ug.

Immunofluorescent analysis of MCF-7 cells using Catalog No:116105(TMEM173 Antibody) at dilution of 1:50 and Alexa Fluor 488-congugated AffiniPure Goat Anti-Rabbit IgG(H+L)

1X10^6 MCF-7 cells were stained with 0.2ug TMEM173 antibody (Catalog No:116105, red) and control antibody (blue). Fixed with 90% MeOH blocked with 3% BSA (30 min). Alexa Fluor 488-congugated AffiniPure Goat Anti-Rabbit IgG(H+L) with dilution 1:1000.
-
Background
TMEM173, also named as ERIS, MITA, STING and MPYS, is a facilitator of innate immune signaling that promotes the production of type I interferon (IFN-alpha and IFN-beta). TMEM173 mediates death signaling via activation of the extracellular signal-regulated kinase (ERK) pathway. There’re monomer (40 kDa) and dimer (80 kDa) form of TMEM173 in western blot test.
-
References
- Malik P, Zuleger N, de las Heras JI. NET23/STING promotes chromatin compaction from the nuclear envelope. PloS one. 9(11):e111851. 2014.
- Liu Y, Li J, Chen J. Hepatitis B virus polymerase disrupts K63-linked ubiquitination of STING to block innate cytosolic DNA-sensing pathways. Journal of virology. 89(4):2287-300. 2015.
- Bhatelia K, Singh A, Tomar D. Antiviral signaling protein MITA acts as a tumor suppressor in breast cancer by regulating NF-κB induced cell death. Biochimica et biophysica acta. 1842(2):144-53. 2014.
Related Products / Services
Please note: All products are "FOR RESEARCH USE ONLY AND ARE NOT INTENDED FOR DIAGNOSTIC OR THERAPEUTIC USE"
